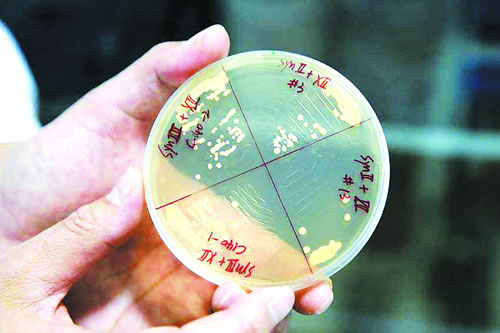

两院院士评选2017年中国、世界十大科技进展新闻揭晓
由中国科学院、中国工程院主办,中国科学院学部工作局、中国工程院办公厅、中国科学报社承办,中国科学院院士和中国工程院院士投票评选的2017年中国十大科技进展新闻、世界十大科技进展新闻,2017年12月31日在京揭晓。
此项年度评选活动至今已举办了24次。评选结果经新闻媒体广泛报道后,在社会上产生了强烈反响,使公众进一步了解国内外科技发展的动态,对宣传、普及科学技术起到了积极作用。
2017年中国十大科技进展新闻
1、我国科学家利用化学物质合成完整活性染色体
我国科学家利用化学物质合成了4条人工设计的酿酒酵母染色体,标志着人类向“再造生命”又迈进一大步。该研究利用小分子核苷酸精准合成了活体真核染色体,首次实现人工基因组合成序列与设计序列的完全匹配,得到的酵母基因组具备完整的生命活性。该研究结果2017年3月10日在《科学》发表,我国也成为继美国之后第二个具备真核基因组设计与构建能力的国家。自2012年开始,天津大学、清华大学和深圳华大基因研究院与美国等国家的科研机构共同推动了酵母基因组合成国际计划(Sc2.0),旨在对酿酒酵母基因组进行人工重新设计和化学再造。我国科学家此次成功合成的4条酿酒酵母染色体,占Sc2.0计划已经合成染色体的2/3。

2、国产水下滑翔机下潜6329米刷新世界纪录
我国自主研发的“海翼”号水下滑翔机于2017年3月在马里亚纳海沟挑战者深渊,完成大深度下潜观测任务并安全回收,最大下潜深度达到6329米,刷新了水下滑翔机最大下潜深度的世界纪录。 “海翼”号水下滑翔机是根据中科院B类战略先导专项的部署,由中科院沈阳自动化所研制的、具有完全自主知识产权的新型水下观测平台。从原理样机的研发到深渊观测任务的圆满完成经历了13个年头,包含浅海、深海、深渊等不同型号的水下滑翔机20余台。此次“海翼”号在马里亚纳海沟共完成了12次下潜工作,总航程超过134.6公里,收集了大量高分辨率的深渊区域水体信息,为海洋科学家研究该区域的水文特性提供宝贵资料。

3、世界首台超越早期经典计算机的光量子计算机诞生
2017年5月3日中国科技大学潘建伟院士科研团队宣布光量子计算机成功构建。潘建伟团队在多光子纠缠领域始终保持着国际领先水平,团队利用自主发展的综合性能国际最优的量子点单光子源,通过电控可编程的光量子线路,构建了针对多光子“玻色取样”任务的光量子计算原型机。实验测试表明,该原型机的取样速度比国际同行类似的实验加快至少24000倍,通过和经典算法比较,也比人类历史上第一台电子管计算机和第一台晶体管计算机运行速度快10倍至100倍。这台光量子计算机标志着我国在基于光子的量子计算机研究方面取得突破性进展,为最终实现超越经典计算能力的量子计算奠定了坚实基础。

4、国产大型客机C919首飞
我国首款国际主流水准的国产大型客机C919于2017年5月5日14时许在上海浦东国际机场首飞。C919的全称是“COMAC919”,COMAC是C919的主制造商中国商飞公司的英文名称简写,“C”既是“COMAC”的第一个字母,也是中国的英文名称“CHINA”的第一个字母,体现了大型客机是国家的意志、人民的期望。第一个9寓意“天长地久”,19寓意C919大型客机最大载客量190人。C919拥有完全自主知识产权,是建设创新型国家的标志性工程,凝聚了国内最优秀的设计人才和工程人才,针对先进的气动布局、结构材料和机载系统,研制人员共规划了102项关键技术攻关,包括飞机发动机一体化设计、电传飞控系统控制律设计、主动控制技术等。

5、我国首次海域天然气水合物试开采
2017年5月18日,我国首次实现海域可燃冰试采成功,南海神狐海域天然气水合物(又称可燃冰)试采实现连续187个小时的稳定产气。这是“中国理论”“中国技术”“中国装备”所凝结而成的突出成就,中国人民又攀登上了世界科技的新高峰。源源不断的天然气从1200多米的深海底之下200多米的底层中开采上来,点燃了全球最大海上钻探平台“蓝鲸一号”的喷火装置。这是我国首次,也是全球首次对资源量占比90%以上、开发难度最大的泥质粉砂型储层可燃冰成功实现试采。从“蓝鲸一号”起步的可燃冰试采,不仅对我国未来的能源安全保障、优化能源结构具有重要意义,甚至可能给世界能源接替研发格局带来改变。

6、我国“人造太阳”装置创造世界新纪录
国家大科学装置——全超导托卡马克核聚变实验装置东方超环(EAST)实现了稳定的101.2秒稳态长脉冲高约束等离子体运行,创造了新的世界纪录。这一重要突破标志着,我国磁约束聚变研究在稳态运行的物理和工程方面将继续引领国际前沿。东方超环是世界上第一个实现稳态高约束模式运行持续时间达到百秒量级的托卡马克核聚变实验装置,对国际热核聚变试验堆(ITER)计划具有重大科学意义。由于核聚变的反应原理与太阳类似,因此,东方超环也被称作“人造太阳”。该成果将为未来ITER长脉冲高约束运行提供重要的科学和实验支持,也为我国下一代聚变装置——中国聚变工程实验堆的预研、建设、运行和人才培养奠定了基础。

7、中国科学家首次发现突破传统分类新型费米子
中国科学院物理研究所科研团队首次发现了突破传统分类的新型费米子——三重简并费米子,为固体材料中电子拓扑态研究开辟了新的方向。这一研究成果于2017年6月19日由《自然》杂志在线发表。寻找新型费米子是近年来拓扑物态领域一个挑战性的前沿科学问题,也是该领域国际竞争的焦点之一。此次新型费米子的发现从理论预言、样品制备到实验观测的全过程,都是由我国科学家独立完成的,它是凝聚态物理中固体理论的一个重要突破。这一研究成果对促进人们认识电子拓扑物态、发现新奇物理现象、开发新型电子器件以及深入理解基本粒子性质都具有重要的意义。

8、量子通信“从理想王国走到现实王国”
2017年1月18日,我国研制的世界首颗量子科学实验卫星“墨子号”在圆满完成4个月的在轨测试后,正式交付使用。2017年6月16日,中国科学技术大学潘建伟、彭承志等带领的团队宣布,利用“墨子号”在国际上率先成功实现了千公里级的星地双向量子纠缠分发,并于此基础上实现了空间尺度下严格满足“爱因斯坦定域性条件”的量子力学非定域性检验。世界首条量子保密通信干线——“京沪干线”于9月29日正式开通。结合“墨子号”卫星,我国科学家成功与奥地利实现了世界首次洲际量子保密通信。“墨子号”圆满实现了三大既定科学目标,用潘建伟的话说,千公里级的星地双向量子通信,终于“从理想王国走到了现实王国”。

9、中科院推出高产水稻新种质
由中科院亚热带农业生态研究所夏新界研究员领衔的水稻育种团队于2017年10月16日宣布,历经十余年研究,团队日前培育出超高产优质“巨型稻”:株高可达2.2米、亩产可达800千克以上、具有高产、抗倒伏、抗病虫害、耐淹涝等特点。经农业部植物新品种测试中心DNA指纹检测,以及华智水稻生物技术有限公司56k水稻SNP基因芯片指纹图谱检测,确认“巨型稻”是一种水稻新种质材料。这种“巨型稻”光合效率高,单位面积生物量比现有水稻品种高出50%,平均有效分蘖40个,单穂最高实粒数达500多粒,单季产量可超过800千克/亩。它是运用突变体诱导、野生稻远缘杂交、分子标记定向选育等一系列育种新技术,获得的水稻新种质材料。

10、“悟空”发现疑似暗物质踪迹
2017年11月30日,中国暗物质粒子探测卫星“悟空”的首批探测成果在《自然》杂志上刊发。“悟空”测量到电子宇宙射线能谱在1.4万亿电子伏特(TeV)能量处的异常波动。这一神秘讯号首次为人类所观测,意味着中国科学家取得了一项开创性发现。如果后续研究证实这一发现与暗物质相关,将是一项具有划时代意义的科学成果,人类就可以跟随着“悟空”的脚步去找寻宇宙中5%以外的广袤未知,这将是一个超出想象的成就。即便与暗物质无关,也可能带来对现有科学理论的突破。“悟空”投入相对小,在“高能电子、伽马射线的能量测量准确度”和“区分不同种类粒子的本领”两项关键技术指标方面世界领先。

特别声明:本站注明稿件来源为其他媒体的文/图等稿件均为转载稿,本站转载出于非商业性的教育和科研之目的,并不意味着赞同其观点或证实其内容的真实性。如转载稿涉及版权等问题,请作者在两周内速来电或来函联系。
